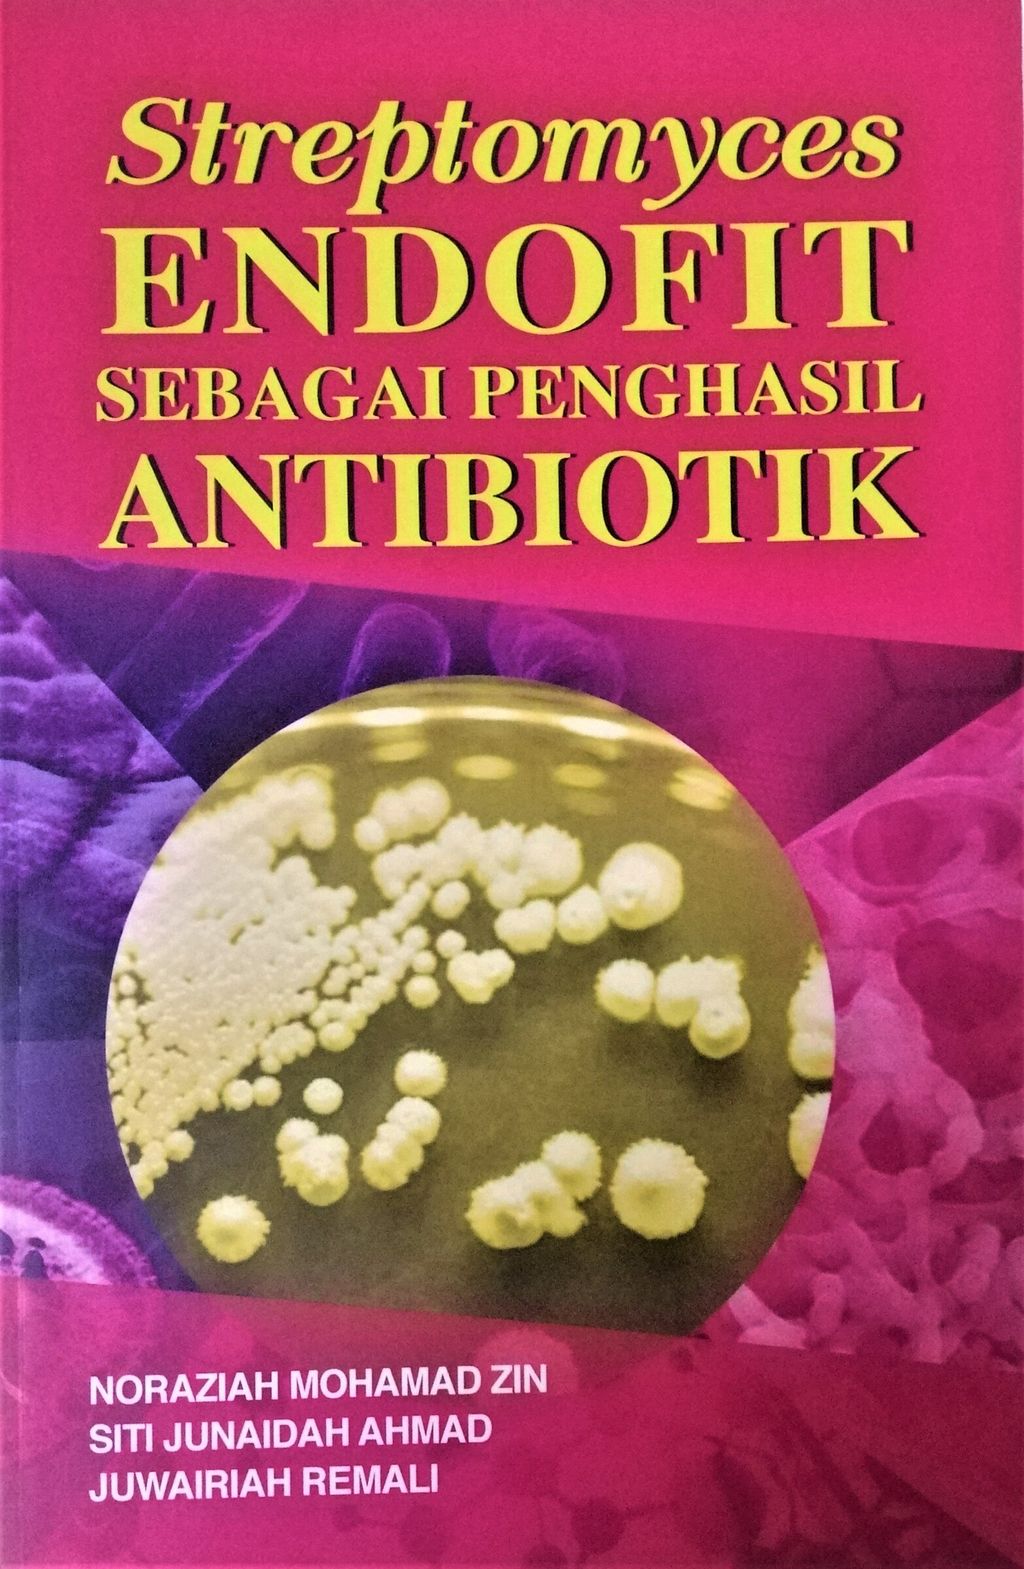
S-Endo

Streptomyces Endofit Sebagai Penghasil Antibiotik
- Regular price
- RM 35.00
- Sale price
- RM 35.00
- Regular price
-
RM 0.00
Share
Streptomyces Endofit Sebagai Penghasil Antibiotik
Author: Noraziah Mohamad Zin, Siti Junaidah Ahmad & Juwairiah Remeli
Publisher: UKM Press
ISBN: 9789672429333
Weight: 0.258kg
Page: 161
Year: 2020
Price: RM35
Buku Streptomyces Endofit Sebagai Penghasil Antibiotik ini adalah gabungan penyelidikan dua orang pelajar peringkat sarjana daripada Kumpulan Penyelidikan Novel Antibiotik UKM. Buku ini dikarang berdasarkan kajian mendalam penghasilan antibiotik daripada sumber natural iaitu bakteria Streptomyces yang dipencilkan dari tumbuhan. Bakteria Streptomyces merupakan bakteria dari kalangan famili aktinobakteria yang telah dibuktikan penghasil antibiotik terbesar deawasa ini. Kajian khusus dari aspek genomik dan metabolomik telah diperincikan di dalam buku ini merangkumi aktiviti sebatian bioaktif daripada Streptomyces sp. terpilih yang telah berupaya merencat pertumbuhan Staphylacoccus aureus rintang methicillin (MRSA) secara in vitro. Kejayaan kumpulan penyelidikan ini di dalam menghasilkan sebatian metabolit sekunder daripada penyelidikan hampir 15 tahun ini meneroka potensi bakteria endofit sebagai agen antiinfeksi dan mengeksplorasi genetik telah dilakar di dalam buku ini. Selain itu juga, interaksi di antara metabolit yang terhasil dan gen yang mengekod metabolit terbabit turut direncanakan di dalam agenda buku ini. Projek penyelidikan ini adalah dibawah tajaan dan naungan beberapa geran penyelidikan iaitu Geran Universiti Penyelidikan FRGS dan juga ERGS. Antara lain, keistimewaan buku ini adalah ia boleh dijadikan rujukan kepada individu yang ingin mendalami dan memahami kebaikan bakteria Streptomyces endofit ini dalam menghasilkan dadah alternatif baru yang boleh dieksplorasi melalui kejuruteraan genetik bagi penghasilan dadah sintetik dari sumber natural.